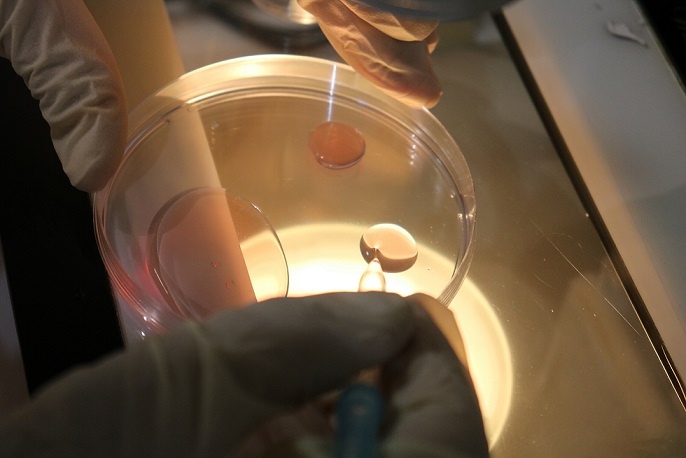
عکس

شرکت دانش بنیان کشت و دامداری فکا

نام واحد فن آور: شرکت دانش بنیان کشت و دامداری فکا
زمینه فعالیت: کشاورزی، دامپروری و دامپزشکیفن آوری و نوآوری: اصلاح نژاد و بهبود راندمان دامپروری و تغییر و ایجاد نژادهای برتر گاوی
محصولات/خدمات:
- فرآورده های ژنتیکی ـ گوساله نر
- فرآورده های ژنتیکی – جنین
- تولید شیرخشک صنعتی
- تو لید شیر خام
- انواع دام
- کود
مدیر عامل: مهندس بهنام مشیری
تلفن همراه : 09133812251
تلفن ثابت : 03136548051
ایمیل شرکت : info@fkaco.ir
وب سایت : www.fkaco.ir
آدرس : اصفهان ابتدای اتوبان ذوب آهن - بعد از ایستگاه اتوبوسرانی BRT - ساختمان شماره 2 مرکز تحقیقات -مرکز رشد کشاورزی و منابع طبیعی اصفهان - واحد 906
برای دریافت اطلاعات بیشتر از( محصولات ، خدمات ، درباره و اطلاعات تماس شرکت) اینجا کلیک کنید...